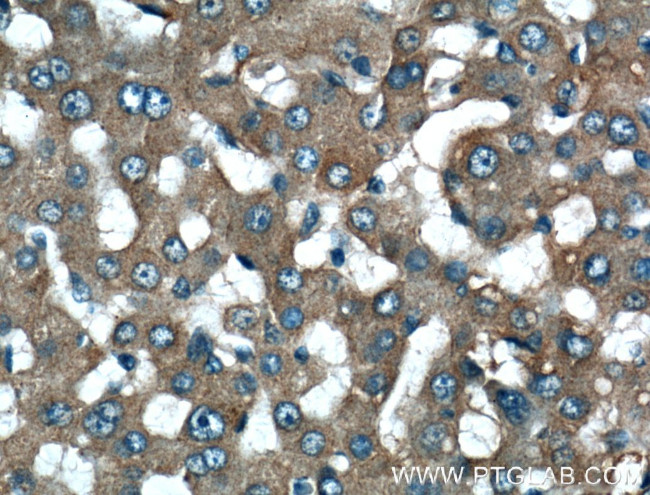
Fibrinogen alpha chain Antibody in Immunohistochemistry (Paraffin) (IHC (P))

Search
Proteintech
Fibrinogen alpha chain Polyclonal Antibody
{{$productOrderCtrl.translations['antibody.pdp.commerceCard.promotion.promotions']}}
{{$productOrderCtrl.translations['antibody.pdp.commerceCard.promotion.viewpromo']}}
{{$productOrderCtrl.translations['antibody.pdp.commerceCard.promotion.promocode']}}: {{promo.promoCode}} {{promo.promoTitle}} {{promo.promoDescription}}. {{$productOrderCtrl.translations['antibody.pdp.commerceCard.promotion.learnmore']}}
产品信息
20645-1-AP
种属反应
已发表种属
宿主/亚型
分类
类型
抗原
偶联物
形式
浓度
规格
纯化类型
保存液
内含物
保存条件
运输条件
产品详细信息
Immunogen sequence: ADSGEGDFL AEGGGVRGPR VVERHQSACK DSDWPFCSGE DWNYKCPSGC RMKGLIDEVN QDFTNRINKL KNSLFEYQKN NKDSHSLTTN IMEILRGDFS SANNRDNTYN RVSEDLRSRI EVLKRKVIEK VTANNLLVAR VTTEETPHLK ARAIKWQMRP EVKPIMKEHI APREAMLNLA LSEVSTLLLW GSLPCPPRLS (20-218 aa encoded by BC020764)
靶标信息
Fibrinogen is a soluble protein found in blood plasma and is produced by the liver cells. The protein is a hexamer consisting of two sets of disulfide linked chains. Fibrinogen is essential for blood coagulation as the precursor of fibrin. It is converted to fibrin by the action of thrombin in the presence of calcium ions.
仅用于科研。不用于诊断过程。未经明确授权不得转售。
生物信息学
蛋白别名: A-alpha fibrinogen; alpha-fibrinogen; alpha-fibrinogen precursor; extended alpha-E variant; Fibrinogen a chain; Fibrinogen alpha; Fibrinogen alpha chain; Fibrinogen α chain; fibrinogen, A alpha polypeptide; Fibrinogenα chain; unnamed protein product
基因别名: AMYLD2; ENSMUSG00000059807; FGA; Fib; Fib2
UniProt ID: (Human) P02671, (Mouse) E9PV24
Entrez Gene ID: (Human) 2243, (Mouse) 14161